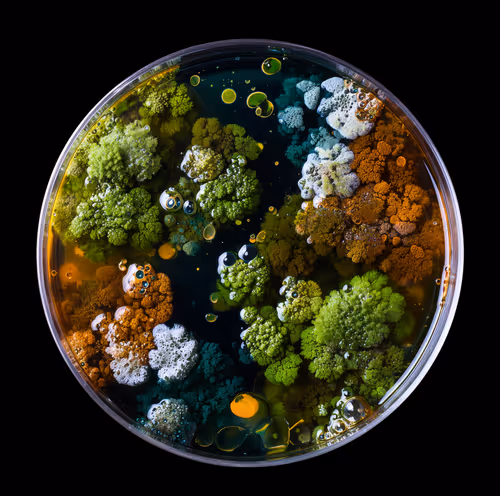
Item #7 Media
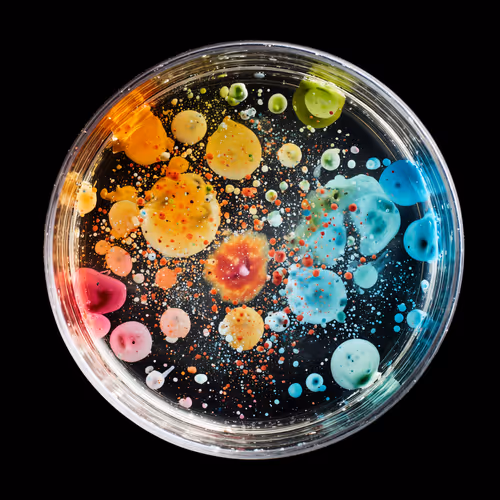
Item #2 Media

Max Price Per ItemMax per item

LIQUID ART
LIQUID ART
Floor price0.100.10 ETH
1d floor %0%
Top offer
—
24h volume0.000.00 ETH
Total volume0.000.00 ETH
Listed54.5%54.5%
Owners (Unique)22 (18.2%18.2% )

LIQUID ARTLIQUID ART
LIQUID ART
LIQUID ART